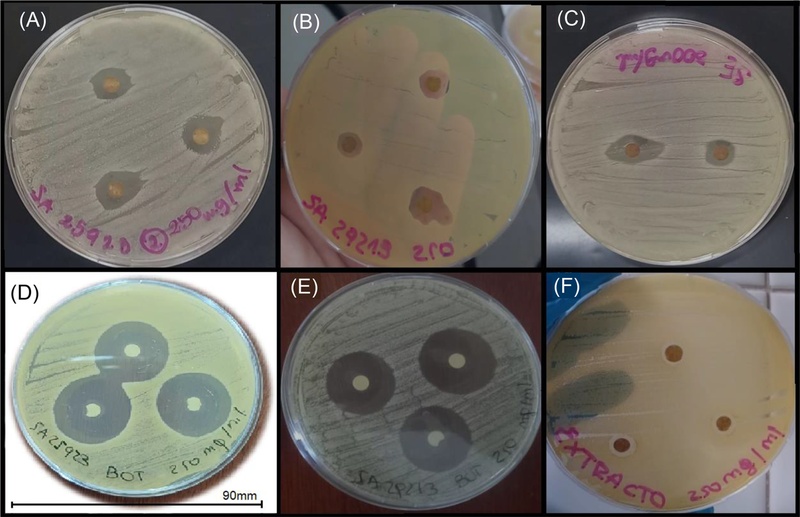
Fig. 2.

Chemical Characterization and Antibacterial Assessment of Cannabis sativa Resins
Abstract
The antibacterial activity of two Cannabis sativa resins, obtained from plants cultivated in Argentina, was evaluated. Both resins were characterized by identifying the cannabinoid and their terpenoid content. One resin (from Los Cocos) was rich in tetrahydrocannabinol, while the other (from San Francisco) was rich in cannabidiol, and both were tested against Gram-positive and Gram-negative bacterial strains. The resins, dissolved in dimethyl sulfoxide, showed greater effectiveness at 250 mg/mL than at 100 mg/mL. The resin from San Francisco was bactericidal at both tested concentrations against strains of Staphylococcus aureus ATCC (25923, 29213, and 6538), Staphylococcus epidermidis ATCC 12228, and Bacillus subtilis subsp. Spizizenii ATCC 6633, while the resin from Los Cocos was effective against Staphylococcus aureus ATCC (25923 and 29213) and Bacillus subtilis subsp. Spizizenii ATCC 6633. Comparing both resins, the minimum inhibitory and minimum bactericidal concentration values for these strains were lower for Los Cocos resin. No bactericidal activity was found against Gram-negative strains of Escherichia coli ATCC 8739, Pseudomonas aeruginosa ATCC 27853, or Salmonella typhimurium ATCC 14028 with either resin tested. The results suggest that Cannabis sativa resins are a promising option for the development of new antimicrobial agents, particularly targeting Gram-positive strains.
Keywords:
Resin, Inhibition, Bactericidal, Cannabis sativaIntroduction
Antibiotic resistance is a major concern in healthcare, as pathogens have developed mechanisms that enable them to survive treatments with antibiotics that were once effective.1 This ongoing resistance has prompted the search for new antimicrobial agents derived from plant extracts, owing to their diverse range of secondary metabolites with antimicrobial properties. The use of plants is a part of alternative and complementary medicine, with origins tracing back to the beginning of human history.2
Phytotherapy, defined as the use of medicinal plants and their derivatives for the prevention and treatment of diseases, has been an essential practice in both traditional and modern medicine. This therapeutic approach utilizes natural bioactive compounds, such as alkaloids, flavonoids, and terpenes, which are found in various plants.3
Cannabis sativa is an angiosperm belonging to the Cannabaceae family, with subspecies sativa, indica, and ruderalis. From the two most commonly cultivated strains, sativa and indica, a range of hybrids has been developed by combining their genetics in varying proportions to achieve desired levels of cannabinoids and therapeutic effects.4 Its medicinal utility has been recognized as early as 2700 B.C., owing to its anti-inflammatory, anticonvulsant, analgesic, sedative, and antimicrobial properties,5 attributed to its chemical families, including terpenes, flavonoids, amino acids, and especially a family of C21 terpenophenolic compounds known as phytocannabinoids, which are unique to this plant. Additionally, it is known that an entourage effect exists between cannabinoids and terpenes, which work synergistically to enhance the physiological effect.6
The most recognized and studied active phytocannabinoids are tetrahydrocannabinol, cannabidiol, cannabinol, and cannabigerol. Tetrahydrocannabinol is the psychoactive component of the plant, whereas cannabidiol is non-psychoactive. Both tetrahydrocannabinol and cannabidiol are neutral cannabinoids, obtained through a decarboxylation process from their acidic forms, such as delta-9-tetrahydrocannabinolic acid and cannabidiolic acid, respectively.7 In Argentina, Law number 27350 establishes the regulatory framework for scientific research on the medicinal, therapeutic, and/or palliative use of cannabis and its derivatives, ensuring and promoting comprehensive health care. With promising advances in medicinal cannabis, the global legalization landscape is evolving rapidly, and Argentina has significant potential for development.8 Consequently, cannabis extracts may represent an effective and safe alternative for the treatment of pain, insomnia, migraines, epilepsy, and as an antimicrobial agent, among other applications.9–11 Several studies have explored the antimicrobial activity of Cannabis sativa against different types of bacteria. For example, Fuentes et al.9 evaluated the antibacterial effect of Cannabis sativa inflorescence and root extracts against various bacteria, including Escherichia coli, Staphylococcus aureus, and Paenibacillus larvae, showing notable in vitro activity especially against Gram-positive bacteria. Kaur et al.12 compared the anti-microbial potency of Cannabis sativa, against four pathogens, which included two Gram-positive bacteria (Staphylococcus aureus MTCC 96 and Bacillus subtilis MTCC 121) and two Gram-negative bacteria (Escherichia coli MTCC 1652 and Pseudomonas aeruginosa MTCC 741). For its part, the review by Niyangoda et al.,13 the antibacterial effects of various cannabinoids, particularly cannabidiol, are evaluated against Staphylococcus aureus and Streptococcus pyogenes, highlighting their in vitro efficacy and potential against resistant strains.
In this study, two Cannabis sativa resins, obtained from plants cultivated in the province of Córdoba (Argentina), were characterized using chromatographic techniques to determine their cannabinoid profiles, while a spectrophotometric methodology was employed to evaluate the terpene and terpenoid contents. Subsequently, the anti-microbial activity of these resins was assessed against pathogenic Gram-positive strains, including Staphylococcus aureus ATCC (25923, 29213, and 6538), Staphylococcus epidermidis ATCC 12228, Bacillus subtilis subsp. Spizizenii ATCC 6633, and pathogenic Gram-negative strains, including Escherichia coli ATCC 8739, Pseudomonas aeruginosa ATCC 27853, and Salmonella typhimurium ATCC 14028. Sensitivity tests were conducted, and the minimum inhibitory concentration (MIC) and minimum bactericidal concentration (MBC) were determined for those strains that demonstrated a significant bactericidal effect.
Experimental
General experimental procedures – Two resins provided by non-profit non-governmental organizations were investigated in the present study. The first one is from the city of San Francisco (Córdoba, Argentina) and was obtained by Soxhlet extraction with ethanol from a hybrid Cannabis sativa plant (50-50 sativa-indica). The second resin is from the city of Los Cocos (Córdoba, Argentina) and was obtained through mechanical pressing with heat from a combination of two different Cannabis sativa strains from Cloud Walker seeds. Both resins were diluted in dimethyl sulfoxide (DMSO, Anedra Research AG, 99.9%) to final concentrations of 100 mg/mL and 250 mg/mL. The choice of this organic solvent for resin dilution was based on various studies.5,9,12,13
Identification and quantification of cannabinoids – Cannabinoid identification was performed using high-performance liquid chromatography (HPLC) with a diode array detector, enabling the identification and quantification of the main active compounds. Calibration curves for each reference cannabinoid in methanolic solution were established. Analyses were conducted using an Agilent 1260 Infinity chromatograph, an Infinity Lab Poroshell 120 ECC18 column (4.6 × 150 mm, 2.7 µm), and a mobile phase consisting of a mixture of water and acetonitrile with 0.1% v/v formic acid with a gradient elution. The solvents employed have a HPLC-grade purity. The analysis time was 10 minutes with a flow rate of 1.5 mL/min, a column oven temperature of 40°C, and a wavelength of 222 nm. For residual solvent control, a limit test based on gas chromatography with headspace injection and flame ionization detector was employed, using an Agilent 6970N chromatograph and a DB624 column.14
The identified compounds included cannabigerol (CBG), cannabidiol (CBD), tetrahydrocannabivarin (THCV), tetrahydrocannabivarinic acid (THCVA), cannabinol (CBN), Δ-9-tetrahydrocannabinol (Δ-9-THC), cannabichromene (CBC), and tetrahydrocannabinolic acid (THCA). Additionally, the total amounts of cannabidiol, total tetrahydrocannabinol, total cannabinoids, THC/CBD ratio, and THC ratio were determined. Cannabinoid content was expressed as % w/w, representing the weight of each cannabinoid relative to the total sample weight.
The potency of the plant material was expressed as the total percentage of neutral cannabinoids present in the sample.4 In this regard, the total cannabidiol content was calculated by adding the CBD content to the cannabidiolic acid (CBDA) content, the latter adjusted by a factor of 0.877 obtained from the ratio between the molecular weight of the acidic form and the neutral form of the molecule. The same criterion and factor were used for the total tetrahydrocannabinol content. The ratio between total THC and CBD content is widely used in cannabis phytotherapy, being an important descriptor of a cannabis variety as a medicine or herbal product.15 The THC:CBD ratio represents the THC to CBD composition present in the sample.
Quantification of total terpene and terpenoid content – The quantification of total terpene and terpenoid content in both resins was performed using a UV-vis spectrophotometric technique described by Aloisio et al.16 For this procedure, a known amount of resin was dissolved in a defined volume of dimethyl sulfoxide. Subsequently, 200 µL of each solution was transferred to 2 mL Eppendorf tubes. To these, 1.5 mL of chloroform and 100 µL of concentrated sulfuric acid were added. After 15 minutes of incubation and an additional 90 minutes in the dark, a reddish-brown precipitate was formed. This precipitate was dissolved in 1.5 mL of 99% methanol. Finally, the absorbance was measured at 538 nm, and the total terpenoid content of each resin was determined using a calibration curve constructed using linalool as standard.
Bacterial strains – Different pathogenic Gram-positive strains were used: Staphylococcus aureus ATCC (25923, 29213, and 6538), Staphylococcus epidermidis ATCC 12228, and Bacillus subtilis subsp. spizizenii ATCC 6633. Additionally, the following pathogenic Gram-negative strains were included: Escherichia coli ATCC 8739, Pseudomonas aeruginosa ATCC 27853, and Salmonella typhimurium ATCC 14028. For all strains, tryptic soy broth solidified with agar was used as culture medium, prepared according to the supplier's specifications. The strains were incubated at 37°C for 24 hours.
The bacterial inoculum was prepared using the direct colony suspension method in saline solution to achieve a density of 0.5 on the McFarland scale, corresponding to approximately 1.5 × 10⁸ CFU/mL.
Sensitivity testing – The sensitivity tests were performed by evaluating both resins at two concentrations using the agar diffusion method.17 Each strain was inoculated by immersing a sterile swab into the corresponding bacterial suspension and evenly spreading it across the surface of a Petri dish containing solidified agar medium, ensuring uniform distribution of microorganisms.
For the sensitivity assays, three sterile filter paper disks (5 mm in diameter) were placed equidistantly on each Petri dish. Each disk was impregnated with 5 μL of the diluted resin. The plates were then incubated at 37°C for 24 hours, and the presence or absence of microbial growth inhibition zones was observed. The antimicrobial extract diffused from the disk into the medium, creating an inhibition zone for strains sensitive to the resin. The diameter of the inhibition zones was measured using a caliper.
To determine whether the tested resin concentrations exhibited inhibitory or bactericidal effects, a sample from the inhibition zone was collected and incubated on tryptic soy agar at 37°C for 24 hours. The presence or absence of bacterial growth was observed, allowing differentiation between bactericidal and inhibitory effects.
This procedure was performed in triplicate for each concentration. Amoxicillin powder was dissolved in water to achieve a concentration of 250 mg/mL which together with dimethyl sulfoxide was used as positive and negative controls, respectively.
Determination of minimum inhibitory concentration (MIC) and minimum bactericidal concentration (MBC) – The minimum inhibitory concentration (MIC) and the minimum bactericidal concentration (MBC) are defined as the lowest concentrations of extract that inhibit bacterial growth or induce the death of 99.9% of the initial bacterial population, respectively, within a predetermined period of time. In this study, the MIC and MBC for the tested resins were determined for bacterial strains that exhibited significant inhibition zones ≥ 12 mm in diameter18 using the broth macrodilution method.17 Tryptic soy broth (1.7% w/v) was used as the culture medium, previously sterilized and distributed in 2 mL aliquots in sterile test tubes. A 0.5 mL aliquot of the resin at a specific concentration was added to the first tube, followed by serial dilutions across six tubes. A control tube containing only the culture medium was included. Each tube was inoculated with a loopful of bacterial inoculum adjusted to a concentration of 1.5 × 10⁵ CFU/mL, ensuring that the preparation and inoculation process was completed within 15 minutes. The tubes were incubated at 37°C for 24 hours. After incubation, bacterial growth was assessed visually by observing turbidity. Tubes without turbidity were further analyzed by plating 10 µL of their contents onto tryptic soy agar plates, which were incubated at 37°C for another 24 hours. The MIC was identified as the lowest concentration of the resin that inhibited visible growth, while the MBC was determined as the lowest concentration that resulted in no growth on the agar plates. The bacterial inoculum was prepared by direct colony suspension in saline solution, as described in the antimicrobial sensitivity assays.
Statistical analysis – The diameters of the inhibition zones were subjected to statistical analysis using the InfoStat program.19 Analysis of variance (ANOVA, α = 0.05) was performed to determine significant differences between the means of the inhibition zone diameters.
Results and Discussion
Table 1 presents the chemical composition (in % w/w) of the resins from San Francisco and Los Cocos. Meanwhile, Fig. 1 shows the HPLC chromatograms of the analyzed resins, expressed in absorbance units (AU). The main cannabinoids present in the Cannabis sativa resin from San Francisco are: cannabidiol (56.78% w/w), cannabichromene (2.55% w/w), cannabigerol (2.22% w/w) and Δ-9-tetrahydrocannabinol (1.87% w/w). On the other hand, the cannabinoids identified in the resin from Los Cocos, listed in decreasing order of concentration, were: Δ-9-Tetrahidrocannabinol (28.41% w/w), tetrahydrocannabinolic acid (22.10% w/w), tetrahydrocannabivarinic acid (3.90% w/w), tetrahydrocannavarin (1.14% w/w), cannabigerol (0.98% w/w), cannabidiol (0.56% w/w), cannabichromene (0.25% w/w) and cannabinol (0.16% w/w). Table 1 shows the differences in the THC/CBD and THC:CBD ratios for both resins. The resin from San Francisco contains a higher amount of cannabidiol than tetrahydrocannabinol, resulting in a THC/CBD ratio of less than 1, whereas the resin from Los Cocos has a ratio greater than 1, indicating a predominance of tetrahydrocannabinol. The optimal THC/CBD ratio depends significantly on the desired effect and individual tolerance. For antimicrobial purposes, it has been suggested that a high cannabidiol-to-tetrahydrocannabinol ratio is the most appropriate for achieving antimicrobial effects.20
Regarding the terpene and terpenoid content of both resins, Table 2 presents the average results of triplicate analyses along with their standard deviations, expressed as mg equivalent of linalool per mg of resin. The San Francisco resin exhibited a significantly higher concentration of these compounds (0.542 mg/mg) compared to the Los Cocos resin (0.279 mg/mg), suggesting that Soxhlet extraction may have favored the recovery of these metabolites compared to mechanical compression. These results align with those reported by Aizpurua-Olaizola et al.,21 who found that the concentration of terpenes and terpenoids in cannabis resins varies depending on the type of extract, cultivation conditions, and typically ranges between 0.1 and 0.3 mg/mg of resin.

Total terpene and terpenoid content, expressed as linalool equivalents in mg/mg of resin, for those originating from San Francisco and Los Cocos
Table 3 shows the results of the sensitivity tests conducted on both resins at concentrations of 100 mg/mL and 250 mg/mL, with amoxicillin (250 mg/mL) as the positive control and pure dimethyl sulfoxide as the negative control. Regarding the analyzed Gram-positive strains, the resin from San Francisco exhibited bactericidal activity at both the 100 mg/mL and 250 mg/mL concentrations against Staphylococcus aureus ATCC (25923, 29213, and 6538), Staphylococcus epidermidis ATCC 12228, and Bacillus subtilis subsp. Spizizenii ATCC 6633, with larger inhibition zones at the higher concentration. In contrast, for the analyzed Gram-negative strains, only an inhibitory effect was observed against Escherichia coli ATCC 8739, with average inhibition zone diameters of 6.9 mm and 9.1 mm at 100 mg/mL and 250 mg/mL concentrations, respectively. Both concentrations were ineffective against Pseudomonas aeruginosa ATCC 27853 and Salmonella typhimurium ATCC 14028.
The resin from Los Cocos showed bactericidal effects for Gram-positive strains at both concentrations against Staphylococcus aureus ATCC (25923 and 29213) and Bacillus subtilis subsp. Spizizenii ATCC 6633, with average inhibition zone diameters of 25.46, 22.56, and 22.3 mm at 100 mg/mL concentration, and 26.53, 23.03, and 24.4 mm at 250 mg/mL concentration, respectively. This resin demonstrated only an inhibitory effect against Staphylococcus aureus ATCC 6538 and Staphylococcus epidermidis ATCC 12228, and was ineffective against the Gram-negative strains of Escherichia coli ATCC 8739, Pseudomonas aeruginosa ATCC 27853, and Salmonella typhimurium ATCC 14028. Both Gram-positive and Gram-negative strains were susceptible to the antibiotic amoxicillin at a concentration of 250 mg/mL, with inhibition zone diameters greater than 12 mm, while pure dimethyl sulfoxide, used as the negative control, was ineffective against all tested strains.
Fig. 2 (A, B, and C) shows the inhibition zone diameters with bactericidal effect of Cannabis sativa resin from San Francisco diluted to 250 mg/mL in dimethyl sulfoxide from San Francisco against Staphylococcus aureus ATCC 25923, Staphylococcus aureus ATCC 29213, and Staphylococcus epidermidis ATCC 12228, respectively. Meanwhile, Fig. 2 (D, E, and F) shows the inhibition zones with the resin from Los Cocos diluted to 250 mg/mL in dimethyl sulfoxide for these same strains. Bacterial strains that exhibited inhibition zones ≥ 12 mm in response to resins diluted at 250 mg/mL in dimethyl sulfoxide were selected for MIC and MBC determinations. These strains included Staphylococcus aureus ATCC (25923, 29213, 6538), Staphylococcus epidermidis ATCC 12228, and Bacillus subtilis subsp. Spizizenii ATCC 6633 for the San Francisco resin, while Staphylococcus aureus ATCC (25923, 29213) and Bacillus subtilis subsp. Spizizenii ATCC 6633 for the Los Cocos resin. All of these are Gram-positive strains, and the values obtained for MIC and MBC are presented in Table 4.
Bactericidal inhibition zones of Cannabis sativa resin from San Francisco and Los Cocos diluted to 250 mg/mL in dimethyl sulfoxide against Staphylococcus aureus ATCC 25923 (A and D), Staphylococcus aureus ATCC 29213 (B and E), Staphylococcus epidermidis ATCC 12228 (C and F), respectively.

Minimum inhibitory concentration and minimum bactericidal concentration values of Cannabis sativa resins
Both Cannabis sativa resins show differences in their antimicrobial properties, as reflected in their MIC and MBC values. As shown in Table 4, the San Francisco resin exhibited MIC and MBC values of 16.7 mg/mL and 50.0 mg/mL, respectively, for Staphylococcus aureus ATCC (25923, 29213, and 6538) and Staphylococcus epidermidis ATCC 12228, and values of 8.3 mg/mL and 50.0 mg/mL for Bacillus subtilis subsp. Spizizenii ATCC 6633. On the other hand, the Los Cocos resin showed MIC and MBC values of 10.9 mg/mL and 32.6 mg/mL, respectively, for Staphylococcus aureus ATCC (25923 and 29213) and Bacillus subtilis subsp. Spizizenii ATCC 6633. Factors such as the cannabinoid and terpene profile, extraction method, plant variety, and cultivation conditions can also influence its antimicrobial efficacy. Research has shown that non-psychoactive cannabinoids such as cannabichromene, cannabigerol, cannabidiol, and cannabinol, as well as the psychoactive Δ-9-tetrahydrocannabinol, exhibit varying degrees of antimicrobial activity.22
Based on this, the Los Cocos resin, with a high Δ-9-tetrahydrocannabinol profile and low cannabidiol, cannabigerol, cannabichromene, and cannabinol content, demonstrated good antimicrobial efficacy, evidenced by lower MIC and MBC values against the Gram-positive strains Staphylococcus aureus ATCC (25923 and 29213) and Bacillus subtilis subsp. Spizizenii ATCC 6633. However, it did not show antimicrobial effects against Staphylococcus aureus ATCC 6538 or Staphylococcus epidermidis ATCC 12228. In contrast, the San Francisco resin, with a high cannabidiol profile and low levels of cannabigerol, cannabichromene, and Δ-9-tetrahydrocannabinol and without cannabinol, exhibited bactericidal inhibition zones against all the Gram-positive strains studied, but with higher MIC and MBC values. This indicates that a higher concentration of resin is required to achieve similar antimicrobial effects.
In our study, neither of the two resins showed bactericidal activity against the tested Gram-negative bacteria. Only mild inhibition was observed for the San Francisco resin against Escherichia coli ATCC 8739. However, both resins demonstrated significant bactericidal activity against the Gram-positive strains studied. The difference in outcomes between the Gram-positive and Gram-negative strains can be attributed to the structural differences in the cell walls of Gram-negative strains. The outer membrane, formed by lipopolysaccharides along with proteins and phospholipids, acts as a barrier, hindering the diffusion of antimicrobial agents, thus making Gram-negative bacteria more resistant to antimicrobial agents.9 This is expected, as Gram-negative strains tend to be more resistant than Gram-positive strains.23 These results are consistent with findings from other studies. For instance, Fuentes et al.9 demonstrated that Cannabis sativa extracts, particularly those obtained from female inflorescences, exhibited strong antibacterial activity against Gram-positive bacteria. The inflorescence extract showed low MIC against Paenibacillus larvae (20.80–76.83 µg/mL) and Staphylococcus aureus (115.25 µg/mL), indicating high potency. In contrast, the root extract was significantly less effective, with MIC exceeding 900 µg/mL. No inhibitory activity was observed against Escherichia coli, a Gram-negative bacterium, for either extract at the tested concentrations. Similarly, Kaur et al.12 compared the antimicrobial potency of Cannabis sativa extracts against two Gram-positive bacteria (Staphylococcus aureus MTCC 96 and Bacillus subtilis MTCC 121) and two Gram-negative bacteria (Escherichia coli MTCC 1652 and Pseudomonas aeruginosa MTCC 741). Their results revealed that the methanolic extract was the most effective, followed by the acetonic and ethanolic extracts. Additionally, they observed that the antimicrobial activity of Cannabis sativa extracts was more pronounced against Gram-positive strains than against Gram-negative ones. Additionally, Appendino et al.22 claims that phytocannabinoids such as tetrahidrocannbidiol, cannabidiol, and cannabigerol have been shown to be effective against Gram-positive bacteria, including methicillin-resistant Staphylococcus aureus strains.
In conclusion, this study evaluated the antibacterial capacity of two resins from the province of Córdoba (Argentina) against several Gram-positive and Gram-negative strains. Dilutions of 250 mg/mL in dimethyl sulfoxide from these resins showed a larger inhibition zone compared to the 100 mg/mL dilutions tested. The San Francisco resin demonstrated bactericidal activity at both concentrations against Staphylococcus aureus ATCC (25923, 29213, and 6538), Staphylococcus epidermidis ATCC 12228, and Bacillus subtilis subsp. Spizizenii ATCC 6633. This resin exhibited inhibition only against Escherichia coli and showed no effect on the other Gram-negative strains. On the other hand, Los Cocos resin was bactericidal against Staphylococcus aureus ATCC (25923 and 29213), and Bacillus subtilis subsp. Spizizenii ATCC 6633. Although it showed an inhibition zone, it was not bactericidal against Staphylococcus epidermidis ATCC 12228 and Staphylococcus aureus ATCC 6538. Furthermore, this resin was ineffective against the analyzed Gram-negative strains. These results suggest that both resins have antimicrobial potential, but their effectiveness varies according to their cannabinoid profile. Specifically, the resin rich in tetrahydrocannabinol (Los Cocos) is more effective against Staphylococcus aureus, while the resin rich in cannabidiol (San Francisco) shows microbial activity across a broader range of strains but requires higher concentrations to achieve the same effect. It is important to note that no bactericidal activity was observed against the Gram-negative strains tested. The choice of the best resin will depend on the context of use and specific treatment goals. The bactericidal potential of Cannabis sativa represents an interesting area for further research, especially considering the rise of antibiotic resistance. However, it is crucial to conduct rigorous studies to validate its therapeutic application in treating infections caused by these pathogens.
Acknowledgments
The authors want to thank Universidad Tecnológica Nacional (UTN, PATCSF0010091TC, PAECSF0008708), the Consejo Nacional de Investigaciones Cientificas y Técnicas (CONICET, PIP 11220200101007CO), and the Ministry of Science and Technology of Córdoba (MinCyT, N105), all from Argentina, for their financial support.
Conflicts of Interest
The authors declare that they have no conflicts of interest.
References
-
Bonini, S. A.; Premoli, M.; Tambaro, S.; Kumar, A.; Maccarinelli, G.; Memo, M.; Mastinu, A. J. Ethnopharmacol. 2018, 227, 300–315.
[https://doi.org/10.1016/j.jep.2018.09.004]

-
ElSohly, M. A.; Radwan, M. M.; Gul, W.; Chandra, S.; Galal, A. In Phytochemistry of Cannabis sativa L.; Kinghorn, A. D.; Falk, H.; Gibbons, S.; Kobayashi, J., Eds.; Springer; United Kingdom, 2017, pp 1–36.
[https://doi.org/10.1007/978-3-319-45541-9_1]

- Mills, S.; Bone, K. Principles and Practice of Phytotherapy: Modern Herbal Medicine; Elsevier: United Kingdom, 2013, pp 3–117.
-
Rovetto, L. J.; Aieta, N. V. J. Supercrit. Fluids. 2017, 129, 16–27.
[https://doi.org/10.1016/j.supflu.2017.03.014]

- Chacón, S. Efecto antibacteriano in vitro del aceite esencial de Cannabis sativa sobre Staphylococcus aureus ATCC 25923 comparado con Gentamicina. Undergraduate Thesis, Universidad Cesar Vallejo. 2020, 1–42.
-
Russo, E. B. Br. J. Pharmacol. 2011, 163, 1344–1364.
[https://doi.org/10.1111/j.1476-5381.2011.01238.x]

-
Turner, C. E.; Elsohly, M. A.; Boeren, E. G. J. Nat. Prod. 1980, 43, 169–234.
[https://doi.org/10.1021/np50008a001]

- Calvo, A. G.; Lampolio, L. Ab-Revista de abogacía. 2021, 9, 27–42.
- Fuentes, G.; Iglesias, A.; Orallo, D.; Fangio, F.; Ramos, F.; Mitton, G.; Fuselli, S.; Maggi, M.; Ramirez, C. L. Biocatal. Agric. Biotechnol. 2023, 47, 102575.
-
Reddy, D. S. Clin. Pharmacol. Ther. 2017, 101, 182–184.
[https://doi.org/10.1002/cpt.441]

-
Hill, K. P.; Palastro, M. D.; Johnson, B.; Ditre, J. W. Cannabis Cannabinoid Res. 2017, 2, 96–104.
[https://doi.org/10.1089/can.2017.0017]

-
Kaur, S.; Sharma, C.; Chaudhry, S.; Aman, R. Res. J. Microbiol. 2015, 10, 280–287.
[https://doi.org/10.3923/jm.2015.280.287]

-
Niyangoda, D.; Aung, M. L.; Qader, M.; Tesfaye, W.; Bushell, M.; Chiong, F.; Tsai, D.; Ahmad, D.; Samarawickrema, I.; Sinnollareddy, M.; Thomas, J. Antibiotics, 2024, 13, 1023.
[https://doi.org/10.3390/antibiotics13111023]

- Caro, Y. S.; Rojido, M. A.; Cámara, M. S.; Zan, M. M. de. 2do Congreso Argentino de Cannabis y Salud. 2021, pp 84–85.
- Vaccarini, C. A. Determinación de cannabinoides en distintas estructuras de la planta de Cannabis sativa sp. y derivados de la misma mediante HPLC/UV-DAD. Undergraduate Thesis, Universidad Nacional de la Plata. 2020, 1–78.
- Aloisio, C.; Longhi, M.; Andreatta, A. E. Lat. Am. J. Pharm. 2024, 43, 2165–2168.
- Clinical and Laboratory Standards Institute. Performance Standards for Antimicrobial Disk Susceptibility Tests: Approved Standard – 11th Edition; Wayne, PA: CLSI, 2012, 32, 1–96.
-
Nostro, A.; Germano, M. P.; D’angelo, V., Marino, A.; Cannatelli, M. A. Lett. Appl. Microbiol. 2000, 30, 379–384.
[https://doi.org/10.1046/j.1472-765x.2000.00731.x]

- Di Rienzo, J. A.; Casanoves, F.; Balzarini, M. G.; Gonzalez, L; Tablada, M; Robledo, C.W. Infostat Software Universidad Nacional del Córdoba. 2011.
-
Grotenhermen, F. Phytocannabinoide. In von Heyden, M.; Jungaberle, H.; Majić, T. (eds). Handbuch Psychoaktive Substanzen. Springer Berlin Heidelberg. 2018, 659–667.
[https://doi.org/10.1007/978-3-642-55125-3_40]

-
Aizpurua-Olaizola, O.; Soydaner, U.; Öztürk, E.; Schibano, D.; Simsir, Y.; Navarro, P.; Etxebarria, N.; Usobiaga, A. J. Nat. Prod. 2016, 79, 324–331.
[https://doi.org/10.1021/acs.jnatprod.5b00949]

-
Appendino, G.; Gibbons, S.; Giana, A.; Pagani, A.; Grassi, G.; Stavri, M.; Smith, E.; Rahman, M. M. J. Nat. Prod. 2008, 71, 1427–1430.
[https://doi.org/10.1021/np8002673]

-
Alberto Fica, C. Revista Médica Clínica Las Condes. 2014, 25, 432–444.
[https://doi.org/10.1016/S0716-8640(14)70060-4]

